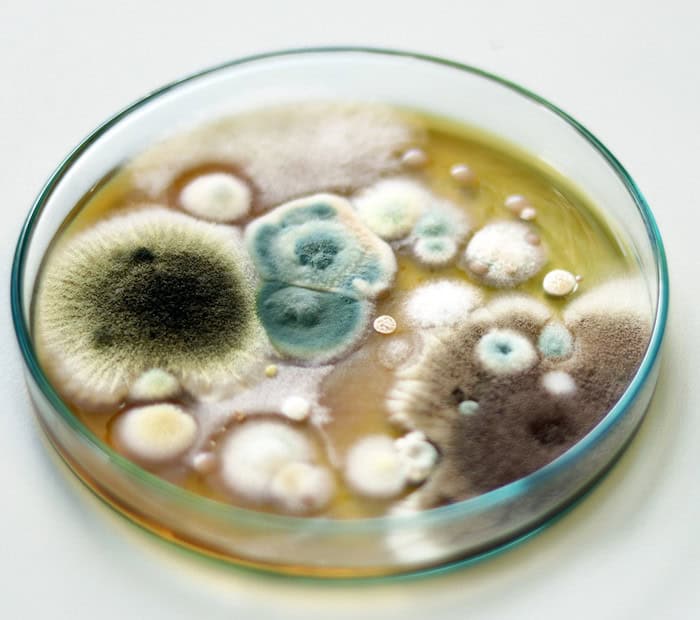
Skimmelsvamp test i petriskål

Skimmelsvamp på badeværelset: 3 effektive metoder til fjernelse og forebyggelse

Badeværelset er boligens mest fugtige og våde rum. Derfor er har skimmelsvamp gode vækstbetingelser på netop badeværelset. Udover at være grimt at se på og at lugte ubehageligt, kan skimmelsvamp udgøre en sundhedsrisiko for dig og din familie.
I denne artikel guider vi dig til, hvordan du effektivt fjerner skimmelsvamp og forebygger, at det opstår igen.
Hvad er skimmelsvamp?
Skimmelsvamp er en type svamp, der trives i fugtige miljøer. Når skimmelsvampen vokser, frigiver den sporer, partikler og kemiske stoffer i luften, som kan være sundhedsskadelige.
Hvis du udsættes for skimmelsvamp over længere tid, kan det medføre symptomer som træthed, hovedpine og åndedrætsbesvær. I værste fald kan det føre til kroniske lidelser som astma og allergi (kilde: Astma-Allergi Danmark).

Hvor opstår skimmelsvamp på badeværelset typisk?
På badeværelset, hvor luftfugtigheden ofte overstiger 70 %, har skimmelsvamp særligt gode vækstbetingelser. Hvis ikke fugten håndteres korrekt, eksempelvis med ventilation, kan problemet hurtigt sprede sig til større områder.
På badeværelset finder du den ofte disse steder:
- Fuger, især omkring brusekabinen eller badekarret
- Hjørner og kroge
- Mellem fliser i fugerne
- Bag toilettet
- Under håndvasken
- På gardiner eller badeforhæng
- I loftet, hvis dampspærren er utæt
Det er almindeligt at have skimmelsvamp på fugerne, især omkring vådzonen i brusekabinen, men det er noget man bør fjerne.
Hvordan opdager jeg skimmelsvamp?
De fleste bemærker skimmelsvampen visuelt. Svampen kan have et markant udseende med gråsorte nuancer, fx i fugerne.
Skimmelsvamp kan dog også være skjult bag bygningsværk og gro i tomrum. I sådanne tilfælde må man bruge sin lugtesans. Skimmel har ligesom sit udseende også en markant lugt af mug.

3 metoder til behandling og rengøring af skimmelsvamp på badeværelset
Fremgangsmåden afhænger af, hvor omfattende angrebet er, og hvor skimmelsvampen befinder sig. Her er tre metoder til at bekæmpe skimmelsvamp på badeværelset:
1. Gør-det-selv fjernelse og rengøring af overfladisk skimmel
Ved mindre angreb på fliser, fuger og andre hårde overflader kan du selv fjerne skimlen:
- Vælg det rigtige produkt: Brug enten et specialmiddel som Protox Hysan (ca. 240 kr.) eller klorin (ca. 30 kr.). Begge midler er effektive mod mindre angreb.
- Forbered området: Brug handsker og maske for at beskytte dig mod kemikalier og svampesporer.
- Påfør midlet: Spray midlet direkte på det angrebne område, og lad det virke i nogle minutter.
- Skrub grundigt: Brug en stiv børste eller svamp til at fjerne svampen og dens sporer. Vær særlig opmærksom på fuger og hjørner.
- Afslut rengøringen: Skyl området med rent vand og tør det grundigt af for at forhindre ny vækst. Vask gardiner og badeforhæng ved 60 grader.
Bemærk, at misfarvninger kan blive siddende, selv efter svampen er fjernet. Det gør sig særligt gældende ved anvendelse af koncentreret klorin.
2. Professionel fjernelse af dybdegående skimmelsvamp
Sidder skimmelsvampen i vægge, gulv eller loft, kan du have brug for professionel hjælp for at sikre en grundig udbedring. En skimmelsvampssanering omfatter typisk:
- Afskærmning samt affræsning af det angrebne område: For at undgå spredning af svampesporer
- Desinfektion og udsugning: Af området for at eliminere resterende svampesporer.
- Montering af nyt, svamperesistent materiale: For at forebygge gentagen vækst.
En professionel svampebekæmper har det rette udstyr og sikkerhedsforanstaltninger til at løse problemet effektivt og ikke mindst viden om at teste for, at skimmelvæksten er fuldstændig saneret.

3. Forebyggende rengøring med naturlige midler
Vil du undgå skrappe kemikalier, findes der flere naturlige midler, der kan hæmme skimmelvækst. Prøv fx at vaske fliser og fuger med:
- Tea tree olie opløst i vand
- Eddike fortyndet med vand
- Hydrogenperoxid (brintoverilte) i en 3% opløsning
Vær dog opmærksom på, at naturlige midler ikke er lige så effektive til at fjerne eksisterende skimmelsvamp. De egner sig bedst som et supplement til den regelmæssige rengøring.
Hvad koster det at få fjernet skimmelsvamp af professionelle?
Er skimmelvæksten på badeværelset omfattende vil det være nødvendigt at involvere professionelle i asbestsaneringen.
Første skridt er en professionel skimmeltest, som typisk inkluderer måling af fugt og identifikation af svampens type, koster fra 2.200 kr. inkl. moms for den første time (kilde: Primabolig.dk).
Omkostningerne til selve fjernelsen varierer afhængigt af, hvor udbredt skimmelsvampen er, og hvilke metoder der kræves. For at få et præcist prisoverslag kan du benytte en tjeneste som 3byggetilbud.dk, hvor du gratis og uforpligtende kan få tilbud fra professionelle fagfolk.
Hvordan forebygger jeg skimmelsvamp på badeværelset?
For at undgå, at skimmelsvamp vender tilbage, bør du tage følgende forholdsregler:
1. Sørg for effektiv udluftning
Luft ud efter hvert bad, så den fugtige luft ledes ud. Lad vinduet eller døren stå åben i mindst 15 minutter, eller indtil luftfugtigheden er tilbage på normalt niveau. Undgå at tørre tøj indenfor.
2. Overvej en badeværelsesventilator
Uanset om der er vindue eller ej, bør badeværelset have en ventilator. En badeværelsesventilator sikrer konstant luftcirkulation og reducerer fugtigheden. Den kan fås i typerne fugtstyret, tidsstyret eller afbryderstyret.
En badeværelsesventilator koster typisk mellem 5-10.000 kr. inkl. montering, el-installationer og diamantboring. Læs mere om badeværelsesventilatorer i vores artikel her.
3. Vedligehold fuger og overflader
Udskift de elastiske fuger hvert 5-10 år for at forhindre fugt i at trænge ind i bygningsmaterialerne. Fugning af brusenichen vil typisk koste mellem 1.000 – 1.500 kr.
Dækker forsikringen skimmelsvamp på badeværelset?
De fleste husforsikringer dækker skimmelsvamp i forbindelse med en dækningsberettiget skade, fx en rørsprængning eller vandskade. Bliver skimmelsvampen konstateret uden en konkret skade, betragtes det dog typisk som manglende vedligehold og er ikke dækket.
Derfor er det afgørende, at du reagerer hurtigt ved tegn på fugt og straks anmelder skaden til forsikringen. Jo hurtigere skaden bliver udbedret, des mindre er risikoen for, at skimmelsvampen når at brede sig.
Kan jeg selv fjerne skimmelsvamp på badeværelset?
Du kan selv klare mindre, overfladiske skimmelangreb med de rette værnemidler og midler som Protox Hysan eller rodalon.
Ved dybdegående og skjult skimmelsvamp i vægge, gulv eller loft bør du overlade saneringen til en professionel svampebekæmper for at sikre, at alt bliver fjernet korrekt.

Kommentarer